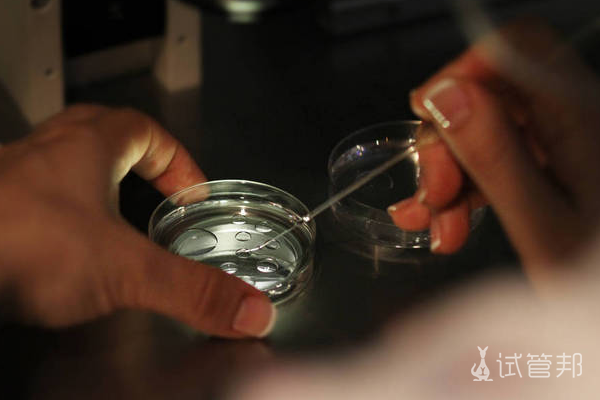
715e8c45ec057bb68b8aaaac340ad7a9.png 上海做试管婴儿费用多少钱

上海做试管婴儿费用多少钱 有哪些流程
随着医学试管婴儿技术的出现和发展,给众多不孕不育家庭带去了极大的生育希望,但随之而来的就是费用问题。那么,上海做试管婴儿费用多少钱呢?做试管婴儿的步骤过程详细有哪些呢?
上海做试管婴儿费用多少钱?
一般情况下,上海单周期试管的费用在3-10万元左右,主要包括:
1、检验费
试管婴儿的术前检查基本都是夫妻双方共同完成,检查费用差别基本不会太大,一般费用在5000-10000元左右。检查的主要原因有:不孕/反复流产原因筛查、夫妻生育能力评估等。
2、药品成本
在做试管婴儿的过程中,需要促进女性排卵。一般促排卵药都是国产的和进口的,而进口的药比较贵。如果用进口药,费用会增加到3-4万。另外,每个女性的年龄、体重、卵巢储备功能都不一样,药物的剂量、注射持续时间也会不一样,所以费用也不一样。
3、手术费用
取卵的费用,胚胎的培养,胚胎移植的手术费用都会算在里面,这些环节的手术费用不会相差太多。另外,因为试管婴儿分为一代、二代、三代,所以费用会有所不同。常规试管婴儿费用在1万元左右,卵胞浆内单精子显微注射费用比常规试管婴儿多4000元左右。第三代试管婴儿技术包括卵胞浆内精子显微注射技术和植入前基因检测技术,所以成本远高于前两代试管婴儿。
做试管婴儿有哪些流程?
1、夫妻双方都要检查一下,看能不能做试管婴儿。
2、携带三证(结婚证、夫妻双方身份证和计划生育机构出具的生育证明),夫妻双方应签署试管婴儿知情同意书。
3、降调,定制专属促排卵方案。
5、抽血做妊娠试验。

在上海做试管婴儿的费用因人而异,若患者本身有疾病,那么就需要治疗,治疗就会产生费用。另外,若女性的年龄过大,也会促使费用增加。此外,想要做试管婴儿的女性一定不要有太大的心理负担及压力,要轻松的做试管,以便获得好的收获。
-
试管婴儿高成功率
点击查看
-
试管婴儿费用/流程
获取详情
-
第三代试管医院
汇总收藏
-
试管婴儿补贴
领取优惠